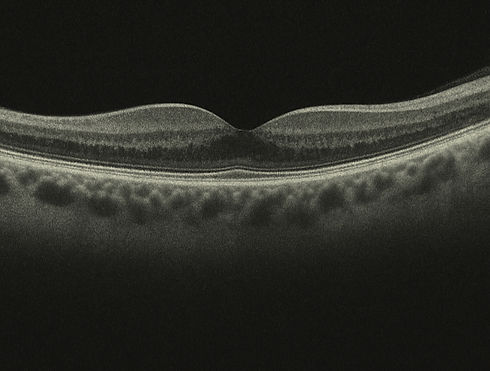
oct_edited.jpg

EMERGENCY CARE
For years, patients have depended on us to provide this valuable service. We offer this and other specialized options to anyone in need of an Optometrist they can trust. Here at Zaker Family Vision, we are dedicated to building long-lasting relationships based on trust and medical integrity with every single patient.

MANAGEMENT OF OCULAR DISEASES
Nothing matters more than your health and comfort when it comes to the treatment of your eyes. We have put so much time and effort into advancing our medical practice, techniques and machines to provide the best care possible. Please get in touch to schedule an initial consultation.
RETINAL IMAGING
Your eye health is our top priority. That's why we offer both retinal photography and OCT (Optical Coherence Tomography) for your exam. Each test gives us a different, but equally important view of your eyes. We can detect eye diseases earlier, track changes over time, and personalize your care and treatment. These tests allow early detection which is key to maintaining lifelong vision.



